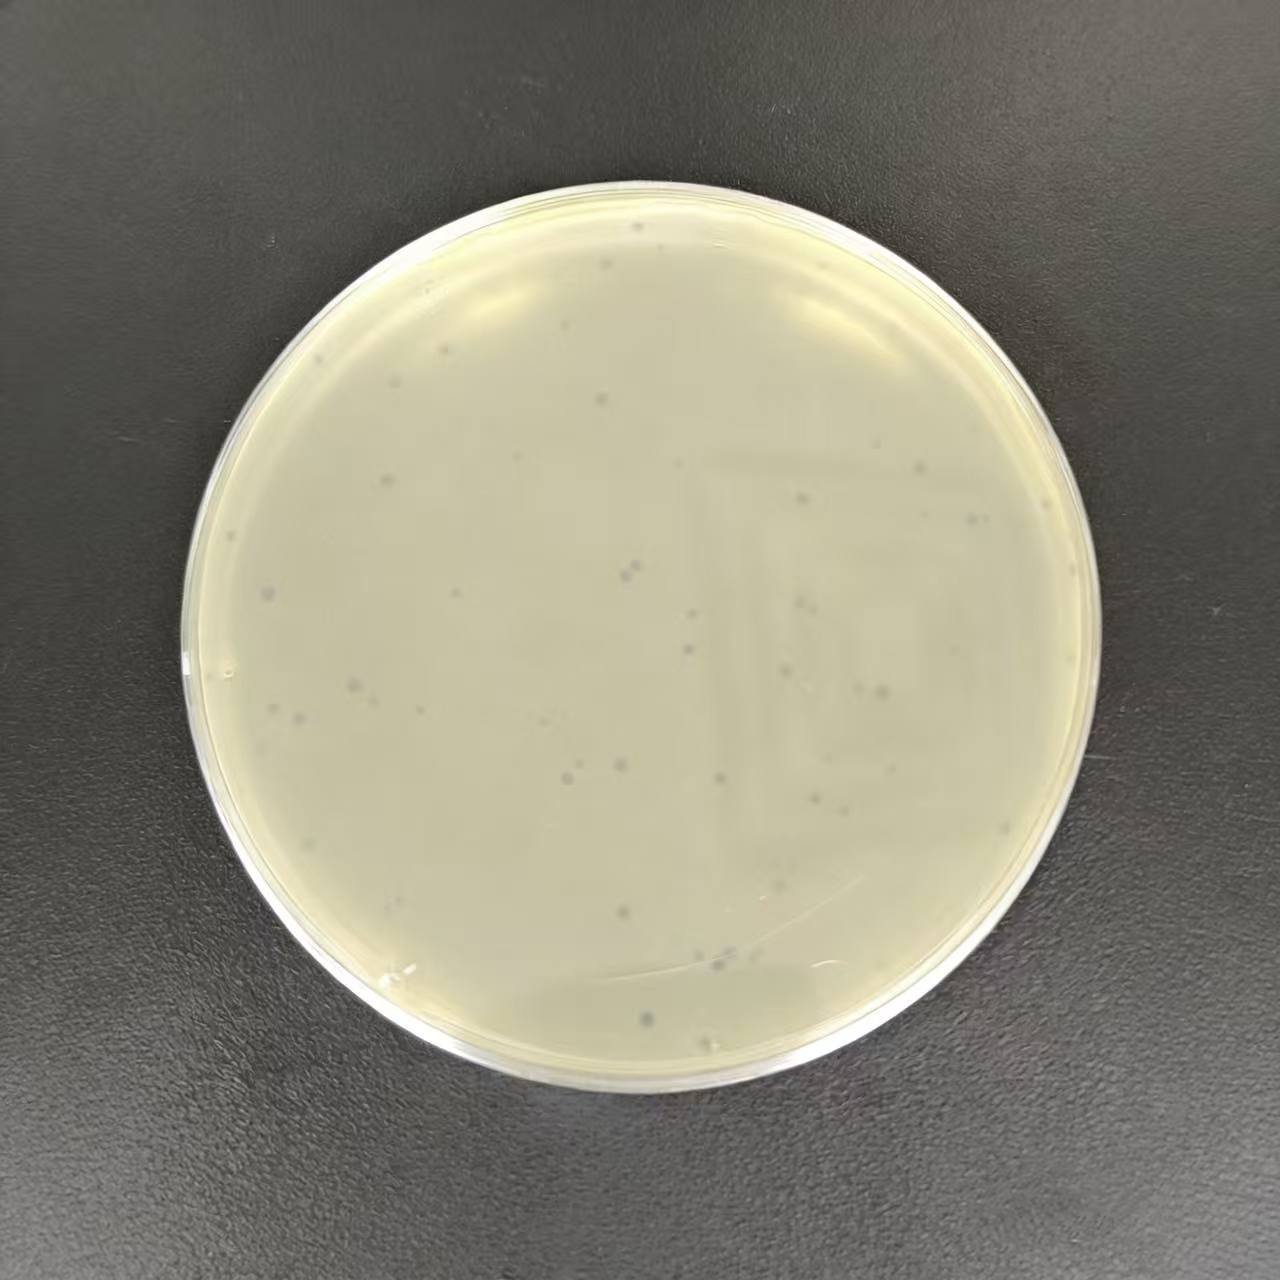
The lysis images of GRS1 against Ralstonia solanacearum in the experiment.

Phagenova-Bacterial wilt
Targeted elimination of Ralstonia solanacearum helps protect the healthy growth of plant.
1.Targeted control of plant diseases caused by Ralstonia solanacearum
2.Protects plant root systems
3.Sustained defense against Ralstonia solanacearum
4.Enhances soil health
Mechanism of action;
1.The Ralstonia solanacearum bacteriophage efficiently lyses its target pathogen, and releases a substantial number of progeny bacteriophages that persist and exert their biocontrol effects in the surrounding environment. This safeguards plant health and provides effective prevention and control against diseases induced by Ralstonia solanacearum.
2.Bacillus amyloliquefaciens and Bacillus megaterium contained in the product rapidly colonize the crop rhizosphere niche; they outcompete pathogenic bacteria for essential nutrients and ecological space, produce bacteriostatic metabolites to suppress the proliferation of harmful microbes, and secrete organic acids that convert soil-borne inorganic and organic phosphorus into absorbable available phosphorus for plant uptake.
1. Bacteriophage Concentration: ≥ 1.0*1010 PFU/kg
2. Bacillus megaterium & Bacillus amyloliquefaciens: Total Viable Beneficial Bacteria Count ≥ 2.0*1011 CFU/kg
Foliar Spraying/Drip Irrigation/Root Drenching: 1 kg per 700m2. Based on soil moisture conditions, adjust the water volume as appropriate to ensure thorough contact between the crop root zone in the soil and the liquid formulation.
Recommended mixing ratio: 1 kg of powder to 600 kg-800kg of water, mixed thoroughly until homogeneous.
【Packaging Specification】1kg/bag 10bags/ctn
【Producing Area】Wuhan,China

Reviews
Clear filtersThere are no reviews yet.